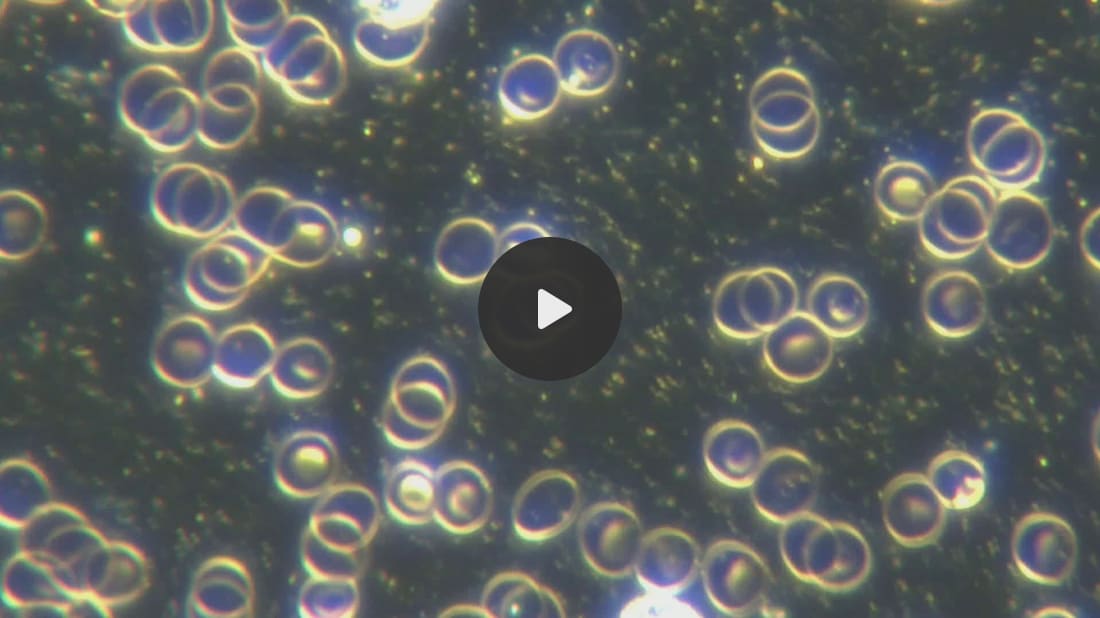

Light
guided microrobotics is what I have been seeing in the human blood and
injectable medications and vaccines now for years. Here is an example in
COVID19 unvaccinated blood of a patient who did receive chemotherapy:
The
nanotechnology literature is exploding with reports of light emitting
microrobots and electronic circuitry made by biodegradable materials.
The overall technocratic agenda of digitizing all life on earth is going
on despite the new year, despite elections, despite wars, despite
drones and UFO sightings. Microrobotics and hybrid materials are of
course used for “cancer cures” just as neuralink brainchips are the
cures for debilitating neurological diseases.
I have discussed the dual use surveillance and warfare purposes of synthetic biology and nanotechnology.
The Rise Of The BioCyborg: Synthetic Biology, Artificial Chimerism And
Human Enhancement"Biodefense
in the Age of Synthetic Biology": Warfare Applications Of Attacking
Populations Through Their Microbiome And Immune System
Smart dust is the same technology in aerosolized form that will also show up in human blood:
Enabling Battlespace Persistent Surveillance: The Form, Function and Future of Smart Dust - Military Warfare 2025 In Effect?
Here is a substack from October 2022 on this topic:
LITERALLY MINDBLOWING: We can AEROSOLIZE NANOBOTS to clump your blood or neuromodulate masses – DARPA expert lectures
Nanowerk had several interesting reports regarding civilian advances in the field:
Light-guided algae microrobots deliver cancer drugs with precision and innovation
The
precise delivery of cancer drugs to tumors has remained one of
medicine's most difficult challenges. Traditional chemotherapy affects
the entire body indiscriminately, while newer targeted therapies often
fail to penetrate deep into tumor tissue. Scientists exploring
microscopic robots as a solution have faced persistent obstacles:
synthetic materials trigger immune responses, chemical propulsion
systems lack precise control, and complex electronics are difficult to
miniaturize safely for use in the body. Meanwhile, photodynamic therapy
emerged as a promising treatment that uses light-activated drugs to
destroy cancer cells. This approach offers precision, as drugs only
become active when exposed to specific wavelengths of light. However,
its effectiveness has been limited by poor drug delivery to tumors and
the low-oxygen environment inside cancer tissue, which reduces the
therapy's potency. The field of biohybrid robotics has
offered potential solutions by combining living cells with synthetic
materials. Bacteria and other microorganisms can swim naturally through
body tissues, but controlling their movement has proved challenging.
Some microorganisms respond to light, magnetic fields, or chemical
gradients, but harnessing these responses for precise medical
applications has remained elusive. Recent advances in molecular
engineering, particularly in modifying cell surfaces and creating
specialized drug carriers, have opened new possibilities. These
techniques allow researchers to attach therapeutic payloads to living
cells while preserving their natural functions. Additionally,
improved understanding of how single-celled organisms navigate and
respond to environmental signals has suggested ways to guide them to
specific locations in the body. Building on these developments,
researchers have now turned to an unlikely source for medical robotics: photosynthetic algae. These
microscopic organisms offer several advantageous properties - they swim
efficiently, respond to light, and naturally produce oxygen through
photosynthesis.
To
create electronics from biological material or to digitize all life on
earth is going on in full force for a long time. Instead of toxic
plastic polymers - as found in the Moderna patent for the COVID19
bioweapon together with unexplained 54 toxic metals used in
semiconductor nanotechnology and fluorescent and paramagnetic
bionanoelectronics - new natural and biodegradable materials are being
used.
Discussion of Argentinian C19 Bioweapon Analysis Finding Building Blocks Of Self Assembly Nanotechnology
These electronic devices are being modified to be biodegradable - however it is still fusion of bilogical life with technology.
Scientists develop biodegradable electronic circuits using mushroom-based materials
Circuit
boards form the foundation of modern electronics, but their production
relies on materials that persist in the environment for centuries. These
boards must meet precise technical requirements: perfectly smooth
surfaces for mounting components, specific electrical properties to
carry signals without interference, and the ability to withstand intense
heat during assembly. Creating alternatives that decompose naturally
while meeting these strict standards has challenged researchers for
decades. Initial attempts at biodegradable electronics failed to match
even basic requirements. Plant-based materials warped under heat.
Bio-plastics couldn't achieve the necessary electrical properties.
Natural fibers proved too rough and irregular for precise circuit
patterns. Each alternative solved one challenge while falling short on
others, leading many to conclude that environmental sustainability would
require compromising performance. A research team at Johannes Kepler
University in Linz, Austria, has now disproven this assumption by
transforming fungal tissue into circuit boards that match conventional
materials in performance while decomposing completely after use. Their
approach targets the fundamental properties of the material rather than
trying to replicate traditional manufacturing processes.
Here is the full assembly of electronic circuitry boards:
I
leave you with this light emitting microrobot in COVID19 unvaccinated
blood. In my clinical practice and personal experience being extremely
sensitive to the effects of shedding, the more of these a person has in
their blood, the worse clinical symptoms like brain fog, fatigue, heart
palpitations get. It is not just the rouleaux formation that is
affecting those symptoms but the interference of the frequency emission
from these microelectronic devices that cause symptoms.
I
have shown how EDTA and Vitamin C, according to the Moderna Patent,
disable the self assembly nano and microrobots in the COVID19 Pfizer
vials:
I recommend the Calcium EDTA by Global Healing.
Global Healing Ca EDTA
You
can find extensive treatment research and case reports in my book
Transhuman Vol 2 and more information on how to look at the body as a
biophotonic and bioelectric entity interfacing with our spiritual self
in Light Medicine - A New Paradigm - The Science of Light, Spirit and Longevity. This knowledge is the very aspects of humanity that are under assault now.
This friday I will be interviewed by Monroe Trainer Luca Biotti about
my first Near Death Experience and the implications of such experiences
for every day life. This will be live streamed at 9 pm Central European
Time. I will post the interview on my substack as well.
We have an exciting journey ahead of us - regardless of the ongoing adversity we are facing!
Transhuman
Light Medicine

No comments:
Post a Comment